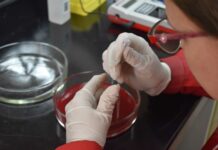
FaCENA FaCENA será sede del «XI Congreso Argentino de Química Analítica»

Inicio 2021
Archivos anuales: 2021
OFERTA INTERNACIONAL Brindan charla informativa sobre becas en Reino Unido
Hasta el 2 de noviembre de 2021 se encuentra abierta la inscripción a las becas Chevening para cursar estudios de posgrado en universidades británicas.
Las...
El avance talibán muestra el fracaso de la intervención de EE.UU. y aliados en...
El profesor Fernando Ariel Bonfanti, docente de Geografía Económica y Política General de la Facultad de Humanidades de la UNNE, se refirió al avance...
Exitoso Encuentro Internacional de Oftalmología
Durante los días viernes 20 y sábado 21 de agosto se escucharon a más 35 oradores en las diferentes subespecialidades de oftalmología.
Participaron, tanto jóvenes...
2° Jornadas Institucionales de Posgrado Inicia el Ciclo de Conferencias 2021 de...
La Secretaría de Posgrado de la Facultad de Odontología de la Universidad Nacional del Nordeste (FOUNNE) ofrecerá un Ciclo de Conferencias, en modalidad virtual,...
FaCENA FaCENA será sede del «XI Congreso Argentino de Química Analítica»
Desde el 30 de noviembre hasta el 3 de diciembre se realizará el "XI Congreso Argentino de Química Analítica". El evento es organizado por...
Reunión informativa Todo lo que hay que saber sobre el acuerdo Internacional: FAU UNNE...
Intercambio de estudiantes de Arquitectura y Diseño Gráfico
Doble titulación en Arquitectura
👉 Descargar Presentación
▶ Ver la Reunión
✉ Consultas: hzurlo@gmail.com
REUNIÓN CON MODALIDAD MIXTA Consejo Asesor de extensionistas de la UNNE: múltiple agenda 2021...
El pasado miércoles 18 de agosto en la sala de Consejo Superior del Rectorado, se realizó una reunión ordinaria del Consejo Asesor de Extensión...
CON INSTITUTO MALBRAN Validan técnicas utilizadas en el Instituto de Medicina Regional para detección...
Mediante una comparación de resultados con el Instituto Malbrán, laboratorio de referencia nacional, el Instituto de Medicina Regional de la UNNE validó la sensibilidad...
Para mejorar la gestión académica y administrativa de sus alumnos La FOUNNE ya utiliza...
La Facultad de Odontología de la Universidad Nacional del Nordeste migró toda la documentación académica del sistema SIU Guaraní 2 al SIU Guaraní 3,...
La pandemia expuso la necesidad de generar información sobre el hábitat de cada territorio
Además del impacto en cuanto a contagios, enfermos y fallecidos, la pandemia de Covid-19, que incluyó el aislamiento social, también expuso las problemáticas del...